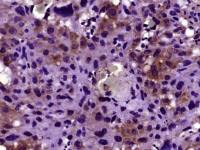
phospho-CD32B(Tyr292) antibody

相关产品推荐更多 >
万千商家帮你免费找货
0 人在求购买到急需产品
- 详细信息
- 技术资料
- 供应商:
上海康朗生物科技有限公司
- 库存:
大量
- 目录编号:
kl-5419R
- 克隆性:
多克隆
- 抗原来源:
Rabbit
- 保质期:
12个月
- 抗体英文名:
phospho-Tau (Thr212) antibody
- 抗体名:
磷酸化微管相关蛋白抗体
- 宿主:
Rabbit
- 适应物种:
Human, Mouse, Rat, Dog, Cow, Horse, Rabbit,
- 免疫原:
KLH conjugated Synthesised phosphopeptide derived from human MAPT isoform 2 around the phosphorylation site of Thr212:SR(p-T)PS
- 亚型:
IgG
- 形态:
冻干粉或液体
- 应用范围:
WB=1:500-2000 ELISA=1:500-1000 IHC-P=1:400-800 IHC-F=1:400-800 IF=1:100-500
- 浓度:
1mg/ml
- 保存条件:
-20 °C
- 规格:
100ul
phospho-Tau (Thr212) antibody
| 中文名称 | 磷酸化微管相关蛋白抗体 |
| 别 名 | Tau (phospho T212); p-Tau (phospho T212); MAPT(phospho T212); MAPT; Microtuble-associted protein Tau; AI413597; AW045860; DDPAC; Disinhibition dementia parkinsonism amyotrophy complex; FLJ31424; FTDP 17; FTDP17; G Protein beta 1 gamma 2 subunit interacting factor 1; G protein beta1/gamma2 subunit interacting factor 1; MAPTL; MGC134287; MGC138549; MGC156663; Microtubule associated protein tau isoform 4; MSTD; Mtapt; MTBT1; MTBT2; Neurofibrillary tangle protein; Paired helical filament tau; PHF tau; PHF-tau; PPND; pTau; RNPTAU; Tauopathy and respiratory failure, included; TAU_HUMAN. |
| 规格价格 | 100ul/1580元 购买 大包装/询价 |
| 说 明 书 | 100ul |
| 产品类型 | 磷酸化抗体 |
| 研究领域 | 免疫学 神经生物学 转录调节因子 |
| 抗体来源 | Rabbit |
| 克隆类型 | Polyclonal |
| 交叉反应 | Human, Mouse, Rat, Dog, Cow, Horse, Rabbit, |
| 产品应用 | WB=1:500-2000 ELISA=1:500-1000 IHC-P=1:400-800 IHC-F=1:400-800 IF=1:100-500 (石蜡切片需做抗原修复) not yet tested in other applications. optimal dilutions/concentrations should be determined by the end user. |
| 分 子 量 | 83kDa |
| 细胞定位 | 细胞浆 细胞膜 |
| 性 状 | Lyophilized or Liquid |
| 浓 度 | 1mg/ml |
| 免 疫 原 | KLH conjugated Synthesised phosphopeptide derived from human MAPT isoform 2 around the phosphorylation site of Thr212:SR(p-T)PS |
| 亚 型 | IgG |
| 纯化方法 | affinity purified by Protein A |
| 储 存 液 | 0.01M TBS(pH7.4) with 1% BSA, 0.03% Proclin300 and 50% Glycerol. |
| 保存条件 | Store at -20 °C for one year. Avoid repeated freeze/thaw cycles. The lyophilized antibody is stable at room temperature for at least one month and for greater than a year when kept at -20°C. When reconstituted in sterile pH 7.4 0.01M PBS or diluent of antibody the antibody is stable for at least two weeks at 2-4 °C. |
| PubMed | PubMed |
| 产品介绍 | background: Tau proteins are important Promotes microtubule assembly and stability, and might be involved in the establishment and maintenance of neuronal polarity. The C-terminus binds axonal microtubules while the N-terminus binds neural plasma membrane components, suggesting that tau functions as a linker protein between both. Axonal polarity is predetermined by tau localization (in the neuronal cell) in the domain of the cell body defined by the centrosome. The short isoforms allow plasticity of the cytoskeleton whereas the longer isoforms may preferentially play a role in its stabilization. Tau proteins subcellular located in the axons of neurons, in the cytoso l and in association with plasma membrane components. It expressed in neurons. PNS-tau is expressed in the peripheral nervous system while the others are expressed in the central nervous system. Function: Promotes microtubule assembly and stability, and might be involved in the establishment and maintenance of neuronal polarity. The C-terminus binds axonal microtubules while the N-terminus binds neural plasma membrane components, suggesting that tau functions as a linker protein between both. Axonal polarity is predetermined by TAU/MAPT localization (in the neuronal cell) in the domain of the cell body defined by the centrosome. The short isoforms allow plasticity of the cytoskeleton whereas the longer isoforms may preferentially play a role in its stabilization. Subunit: Interacts with PSMC2 through SQSTM1. Interacts with SQSTM1 when polyubiquitinated. Interacts with FKBP4. Binds to CSNK1D. Interacts with SGK1. Subcellular Location: Cytoplasm, cytosol. Cell membrane; Peripheral membrane protein; Cytoplasmic side. Cytoplasm, cytoskeleton. Cell projection, axon. Note=Mostly found in the axons of neurons, in the cytosol and in association with plasma membrane components. Tissue Specificity: Expressed in neurons. Isoform PNS-tau is expressed in the peripheral nervous system while the others are expressed in the central nervous system. Post-translational modifications: Phosphorylation at serine and threonine residues in S-P or T-P motifs by proline-directed protein kinases (PDPK1: CDK1, CDK5, GSK3, MAPK) (only 2-3 sites per protein in interphase, seven-fold increase in mitosis, and in the form associated with paired helical filaments (PHF-tau)), and at serine residues in K-X-G-S motifs by MAP/microtubule affinity-regulating kinase (MARK1 or MARK2), causing detachment from microtubules, and their disassembly. Phosphorylation decreases with age. Phosphorylation within tau/MAP's repeat domain or in flanking regions seems to reduce tAU/MAP's interaction with, respectively, microtubules or plasma membrane components. Phosphorylation on Ser-610, Ser-622, Ser-641 and Ser-673 in several isoforms during mitosis. Phosphorylation at Ser-548 by GSK3B reduces ability to bind and stabilize microtubules. Phosphorylation at Ser-579 by BRSK1 and BRSK2 in neurons affects ability to bind microtubules and plays a role in neuron polarization. Phosphorylated at Ser-554, Ser-579, Ser-602, Ser-606 and Ser-669 by PHK. Phosphorylation at Ser-214 by SGK1 mediates microtubule depolymerization and neurite formation in hippocampal neurons. There is a reciprocal down-regulation of phosphorylation and O-GlcNAcylation. Phosphorylation on Ser-717 completely abolishes the O-GlcNAcylation on this site, while phosphorylation on Ser-713 and Ser-721 reduces glycosylation by a factor of 2 and 4 respectively. Phosphorylation on Ser-721 is reduced by about 41.5% by GlcNAcylation on Ser-717. Polyubiquitinated. Requires functional TRAF6 and may provoke SQSTM1-dependent degradation by the proteasome. PHF-tau can be modified by three different forms of polyubiquitination. 'Lys-48'-linked polyubiquitination is the major form, 'Lys-6'-linked and 'Lys-11'-linked polyubiquitination also occur. O-glycosylated. O-GlcNAcylation content is around 8.2%. There is reciprocal down-regulation of phosphorylation and O-GlcNAcylation. Phosphorylation on Ser-717 completely abolishes the O-GlcNAcylation on this site, while phosphorylation on Ser-713 and Ser-721 reduces O-GlcNAcylation by a factor of 2 and 4 respectively. O-GlcNAcylation on Ser-717 decreases the phosphorylation on Ser-721 by about 41.5%. Glycation of PHF-tau, but not normal brain TAU/MAPT. Glycation is a non-enzymatic post-translational modification that involves a covalent linkage between a sugar and an amino group of a protein molecule forming ketoamine. Subsequent oxidation, fragmentation and/or cross-linking of ketoamine leads to the production of advanced glycation endproducts (AGES). Glycation may play a role in stabilizing PHF aggregation leading to tangle formation in AD. DISEASE: Note=In Alzheimer disease, the neuronal cytoskeleton in the brain is progressively disrupted and replaced by tangles of paired helical filaments (PHF) and straight filaments, mainly composed of hyperphosphorylated forms of TAU (PHF-TAU or AD P-TAU). O-GlcNAcylation is greatly reduced in Alzheimer disease brain cerebral cortex leading to an increase in TAU/MAPT phosphorylations. Defects in MAPT are a cause of frontotemporal dementia (FTD) [MIM:600274]; also called frontotemporal dementia (FTD), pallido-ponto-nigral degeneration (PPND) or historically termed Pick complex. This form of frontotemporal dementia is characterized by presenile dementia with behavioral changes, deterioration of cognitive capacities and loss of memory. In some cases, parkinsonian symptoms are prominent. Neuropathological changes include frontotemporal atrophy often associated with atrophy of the basal ganglia, substantia nigra, amygdala. In most cases, protein tau deposits are found in glial cells and/or neurons. Defects in MAPT are a cause of Pick disease of the brain (PIDB) [MIM:172700]. It is a rare form of dementia pathologically defined by severe atrophy, neuronal loss and gliosis. It is characterized by the occurrence of tau-positive inclusions, swollen neurons (Pick cells) and argentophilic neuronal inclusions known as Pick bodies that disproportionally affect the frontal and temporal cortical regions. Clinical features include aphasia, apraxia, confusion, anomia, memory loss and personality deterioration. Note=Defects in MAPT are a cause of corticobasal degeneration (CBD). It is marked by extrapyramidal signs and apraxia and can be associated with memory loss. Neuropathologic features may overlap Alzheimer disease, progressive supranuclear palsy, and Parkinson disease. Defects in MAPT are a cause of progressive supranuclear palsy type 1 (PSNP1) [MIM:601104]; also abbreviated as PSP and also known as Steele-Richardson-Olszewski syndrome. PSNP1 is characterized by akinetic-rigid syndrome, supranuclear gaze palsy, pyramidal tract dysfunction, pseudobulbar signs and cognitive capacities deterioration. Neurofibrillary tangles and gliosis but no amyloid plaques are found in diseased brains. Most cases appear to be sporadic, with a significant association with a common haplotype including the MAPT gene and the flanking regions. Familial cases show an autosomal dominant pattern of transmission with incomplete penetrance; genetic analysis of a few cases showed the occurrence of tau mutations, including a deletion of Asn-613. Defects in MAPT are a cause of Parkinson-dementia syndrome (PARDE) [MIM:260540]. A syndrome characterized by parkinsonism tremor, rigidity, dementia, ophthalmoparesis and pyramidal signs. Neurofibrillary degeneration occurs in the hippocampus, basal ganglia and brainstem nuclei. Similarity: Contains 4 Tau/MAP repeats. SWISS: P10636 Gene ID: 4137 Database links: Entrez Gene: 281296 Cow Entrez Gene: 4137 Human Entrez Gene: 17762 Mouse Entrez Gene: 29477 Rat Omim: 157140 Human SwissProt: P29172 Cow SwissProt: P10636 Human SwissProt: P10637 Mouse SwissProt: P19332 Rat Unigene: 101174 Human Unigene: 1287 Mouse Unigene: 2455 Rat Important Note: This product as supplied is intended for research use only, not for use in human, therapeutic or diagnostic applications. P-tau蛋白是脑内神经元细胞支架蛋白之一。其正常功能是促进微管蛋白组成微管,并维持已形成微管的稳定性。参与维持细胞形态、信息传递、细胞分裂等重要生物学过程,是轴突生长发育和神经元极性形成的不可缺少因素。近年来发现tau蛋白与一些中枢神经系统变性疾病密切相关,尤其是神经Tau具有启动微管系统的装配以及稳定微管系统的作用,该蛋白的错误折叠与老年性痴呆等神经退行性疾病密切相关。 |
风险提示:丁香通仅作为第三方平台,为商家信息发布提供平台空间。用户咨询产品时请注意保护个人信息及财产安全,合理判断,谨慎选购商品,商家和用户对交易行为负责。对于医疗器械类产品,请先查证核实企业经营资质和医疗器械产品注册证情况。
技术资料暂无技术资料 索取技术资料
phospho-Tau (Thr212) antibody
¥1580